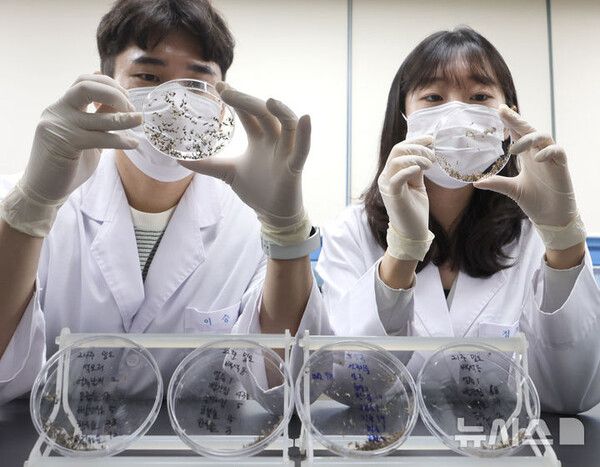

폭우와 폭염이 반복되는 기후에 따라 감염병이 확산할 위험이 커지고 있다. 오염된 물과 음식, 모기 등을 통해 전파되는 감염병에 대한 주의가 요구된다.
뉴시스 보도에 따르면, 20일 한국건강관리협회 대구지부에 따르면 폭우와 폭염이 반복되는 여름철은 오염된 지하수와 식재료, 모기나 파리 같은 해충의 개체 수가 증가해 감염병 확산이 쉬운 시기다.
특히 면역력이 취약한 어린이와 노인, 기저질환자의 경우 감염 시 중증으로 진행될 가능성이 높아 세심한 관리가 요구된다.
◆모기 매개 감염병, 물리지 않도록 주의하고 주변 환경 정비해야
폭우로 생긴 물웅덩이는 모기의 산란 장소가 돼 모기 개체수를 급증시킨다. 이에 따라 일본뇌염과 말라리아 등 모기 매개 감염병이 발생할 가능성이 높아진다.
일본뇌염은 일본뇌염 바이러스에 감염된 작은 빨간집모기에 의해 발생한다. 이 병에 걸리면 고열, 두통, 구토, 의식장애 등 증상을 보이며 사망에 이를 수도 있다.
예방법으로는 모기가 왕성하게 활동하는 저녁과 새벽 시간에는 외출을 자제해야 한다. 외출 시에는 긴팔과 긴바지를 입어 노출을 최소화하고 모기기피제를 사용하는 것이 좋다.
집 주변의 물웅덩이나 하수구 등을 청소해 모기 서식지를 없애고 방충망에 틈새가 없는지도 확인해야 한다.
◆수인성·식품 매개 감염병, 깨끗한 물과 음식 섭취해야
폭우로 상하수도 시설이 범람하거나 오염된 물이 유입되면 장티푸스와 세균성 이질 등와 같은 수인성·식품 매개 감염병이 확산할 수 있다.
장티푸스는 오염된 물이나 음식물을 섭취함에 따라 발생한다. 증상으로는 고열, 두통, 복통, 설사 등이 나타난다.
세균성 이질도 같은 경로를 통해 감염된다. 10∼100개의 적은 양의 세균으로도 감염될 만큼 전염성이 높다. 증상으로는 발열, 복통, 혈액성 설사 등이 있다.
만약 이러한 증상이 나타나면 즉시 병원을 방문해 진료를 받아야 한다. 특히 설사가 심할 때는 탈수 증상이 나타날 수 있으므로 충분한 수분 보충이 필수다.
물은 반드시 끓여 마시거나 안전한 생수를 이용해야 한다. 음식은 충분히 익혀서 섭취하고 조리된 음식은 가급적 빨리 먹는 것이 좋다.
◆접촉성 감염병, 피부 노출 최소화하고 상처 관리해야
침수된 지역에서 작업하거나 오염된 물과 흙에 상처가 노출될 경우 렙토스피라증과 파상풍 등에 감염될 수 있다.
렙토스피라증은 렙토스피라균에 오염된 물이나 동물 소변을 통해 감염된다. 고열과 두통 등의 증상을 보이며 심하면 신부전이나 폐출혈을 일으킬 수 있다.
파상풍은 상처 부위에 파상풍균이 침입했을 때 발생한다. 근육의 경련성 마비와 통증을 동반한 근육수축을 일으킨다.
이들 감염병을 예방하려면 침수 지역에서 작업할 때 방수 장갑과 장화 등 보호장비를 반드시 착용해 피부 노출을 최소화해야 한다.
몸에 상처가 있다면 방수 밴드를 붙여 오염을 막고 작업 후에는 상처 부위를 소독해야 한다. 파상풍 예방 접종은 면역력을 유지하기 위해 10년마다 하는 것이 좋다.
건강관리협회 대구지부 관계자는 "각 감염병의 구체적인 증상과 예방수칙을 숙지해 의심 증상 발생 시 신속히 적절한 치료를 받는 것이 중요하다"고 말했다.
Copyright ⓒ 모두서치 무단 전재 및 재배포 금지
본 콘텐츠는 뉴스픽 파트너스에서 공유된 콘텐츠입니다.



